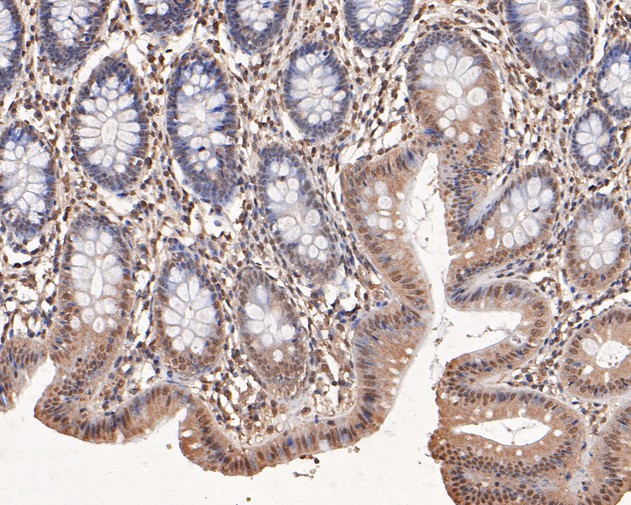
PP-X Antibody in Immunohistochemistry (Paraffin) (IHC (P))

Search
Huabio
PP-X Polyclonal Antibody
{{$productOrderCtrl.translations['antibody.pdp.commerceCard.promotion.promotions']}}
{{$productOrderCtrl.translations['antibody.pdp.commerceCard.promotion.viewpromo']}}
{{$productOrderCtrl.translations['antibody.pdp.commerceCard.promotion.promocode']}}: {{promo.promoCode}} {{promo.promoTitle}} {{promo.promoDescription}}. {{$productOrderCtrl.translations['antibody.pdp.commerceCard.promotion.learnmore']}}
图: 1 / 2
PP-X Antibody (HA500276) in IHC (P)


产品信息
HA500276
种属反应
宿主/亚型
分类
类型
抗原
偶联物
形式
浓度
规格
纯化类型
保存液
内含物
保存条件
运输条件
靶标信息
The protein encoded by this gene is one subunit of a trimeric complex, forming a highly conserved transcription factor that binds to CCAAT motifs in the promoter regions in a variety of genes. Subunit A associates with a tight dimer composed of the B and C subunits, resulting in a trimer that binds to DNA with high specificity and affinity. The sequence specific interactions of the complex are made by the A subunit, suggesting a role as the regulatory subunit. In addition, there is evidence of post-transcriptional regulation in this gene product, either by protein degradation or control of translation. Further regulation is represented by alternative splicing in the glutamine-rich activation domain, with clear tissue-specific preferences for the two isoforms.
仅用于科研。不用于诊断过程。未经明确授权不得转售。
篇参考文献 (0)
生物信息学
蛋白别名: epididymis secretory sperm binding protein; P PPX; PP-X; PP4C; protein phosphatase 4 (formerly X), catalytic subunit; Protein phosphatase X; protein phosphatase X, catalytic subunit; Serine/threonine-protein phosphatase 4 catalytic subunit
基因别名: PP-X; PP4; PP4C; PPH3; PPP4; PPP4C; PPX
UniProt ID: (Human) P60510
Entrez Gene ID: (Human) 5531